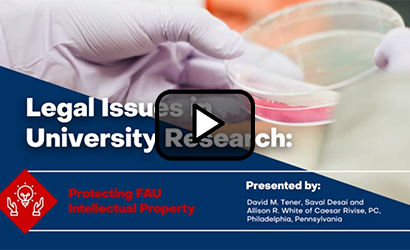

From Campus to Community: Protection & Public Adoption of Social Innovations
Watch Video
Videos


Navigating Drug, Biologic, and Device Regulatory Strategies
Watch Video

Commercializing Research Tools: Increasing the Visibility and Impact of Your Research
Watch Video

Patent Protection for AI, Software and Algorithmic Innovations
Watch Video

How to Start a Company Based on Your Research
Watch Video

Patenting Life Science and Medical Device Innovations
Watch Video

How to Pitch Your Research to Industry

Ask the Expert: How Do I Protect My Research?
Watch Video

Ask the Expert: How Do I Commercialize My Research?
Watch Video
Legal Issues in University Research: Protecting FAU Intellectual Property
Watch Video

Bringing FAU Innovations to Market: Commercializing University Research
Watch Video

FAU Office of Technology Development

Introduction to Technology Transfer and Intellectual Property
Video not available.